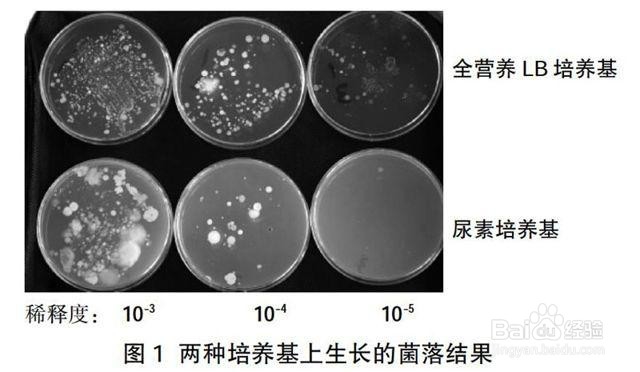
以氯化铵为氮源肥料，全部施用化肥的施肥方法

以氯化铵为氮源肥料,全部施用化肥的施肥方法
1、首先,目前池塘施用化肥,一般都以氨水、碳酸氢铵、硫酸铵和尿素等作氮源肥料,而很少施用氯化铵。再用氯化铵作氮源化肥,同时施用过磷酸钙,取得大面积养鱼的较高产量和施肥效果。

2、然后,池塘饲养鲢鱼、鳙鱼、草鱼、团头鲂和鲤鱼,鲢鱼、鳙鱼放养量占总放养量的50%~60%,每亩净产链鱼、鳙鱼260千克左右(其他鱼类亩净产210千克左右)。池塘水深,5 月份前一般为1.5米左右,5月份后为1.8米左右。

3、然后,饲养期间向草鱼、团头鲂和鲤鱼投喂大麦和青饲料(黑麦草、苏丹草),肥料全部施用氯化铵[含氮(N)25%]和过磷酸钙[含磷(P2O )12%J。施肥期为4~10月份。施肥量和施肥次数依不同季节的水温而增减。
4、然后,氯化铵以氮(N)的浓度计算,前期水温为20 C左右时,每次施肥氮(N)的浓度为1~1.25ppm,每月施3~4次,以后随水温升高,每次施肥量减少,施肥次数增加:20~25C时每次为0.75~1ppm,每月4~5次;25C以上时每次为0.5~0.75ppm,每月6~7 次。

5、然后,每次施氯化铵的同时施以氮(N) :磷(P2O;)=1:0.5浓度的过磷酸钙。氮、磷比过高过低均不利,若氦:磷一1:0.33,则浮游植物生产量将受到限制;而氦:磷=1:1时,则磷肥的损失大,成本也高。

6、最后,施肥时还须根据具体情况灵活掌握施肥量,如饲养前期鱼体较小,投饲量较少,如水质不肥,可适当增加施肥量;相反,饲养后期水质易过肥,则应控制施肥量。

声明:本网站引用、摘录或转载内容仅供网站访问者交流或参考,不代表本站立场,如存在版权或非法内容,请联系站长删除,联系邮箱:site.kefu@qq.com。
阅读量:160
阅读量:125
阅读量:182
阅读量:142
阅读量:120